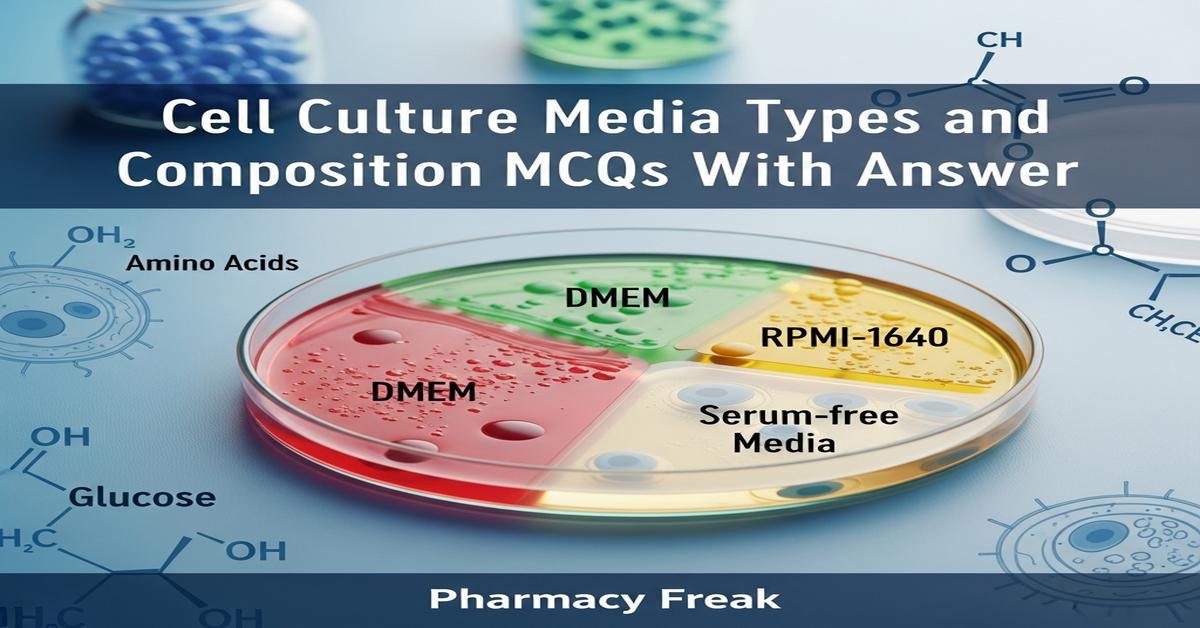
Cell culture media types and composition MCQs With Answer

Introduction: This quiz collection on Cell culture media types and composition is designed for M.Pharm students preparing for Modern Bio-Analytical Techniques (MPA 202T). It focuses on the principles, classification and components of media used for mammalian cell culture, including basal versus complete media, defined and complex formulations, buffering systems, energy substrates, supplements such as serum, glutamine and pyruvate, and practical aspects like sterilization and contamination control. Each question tests conceptual understanding and applied knowledge needed for experimental design and troubleshooting in pharmacological and biotechnological research involving cultured cells.
Q1. Which statement correctly distinguishes a basal medium from a complete medium?
- Basal medium contains serum and full supplements; complete medium lacks serum and additives.
- Basal medium provides basic salts, amino acids and vitamins; complete medium has basal components plus serum and/or defined supplements.
- Basal medium is always serum-free and used only for bacteria; complete medium is for mammalian cells.
- Basal medium includes antibiotics to prevent contamination; complete medium is antibiotic-free.
Correct Answer: Basal medium provides basic salts, amino acids and vitamins; complete medium has basal components plus serum and/or defined supplements.
Q2. Which description best defines a chemically defined (synthetic) medium?
- A medium containing serum and complex extracts where exact composition is unknown.
- A medium in which every component and concentration is known and generally lacks serum.
- A medium prepared from tissue extracts and conditioned fluids.
- A medium made from powdered animal blood products for primary cells.
Correct Answer: A medium in which every component and concentration is known and generally lacks serum.
Q3. What are the principal roles of fetal bovine serum (FBS) when added to culture media?
- Act strictly as an antibiotic and prevent fungal growth.
- Provide growth factors, hormones, attachment factors, carrier proteins and additional nutrients to support cell proliferation.
- Mainly adjust osmolality and replace bicarbonate buffering.
- Serve only as a pH indicator similar to phenol red.
Correct Answer: Provide growth factors, hormones, attachment factors, carrier proteins and additional nutrients to support cell proliferation.
Q4. Which basal medium is commonly used for adherent mammalian cells and is available in low- and high-glucose formulations?
- RPMI 1640
- DMEM (Dulbecco’s Modified Eagle Medium)
- Ham’s F-12
- LB broth
Correct Answer: DMEM (Dulbecco’s Modified Eagle Medium)
Q5. Which pair of glucose concentrations correspond approximately to “low” and “high” glucose DMEM formulations?
- 0.1 g/L and 1.0 g/L
- 1.0 g/L (≈5.5 mM) and 4.5 g/L (≈25 mM)
- 5 g/L and 10 g/L
- 10 g/L and 20 g/L
Correct Answer: 1.0 g/L (≈5.5 mM) and 4.5 g/L (≈25 mM)
Q6. Which buffering system is appropriate for maintaining pH in media when cultures are handled outside a CO2 incubator?
- Bicarbonate/CO2 buffer alone
- HEPES buffer
- Phenol red
- Glucose-based buffering
Correct Answer: HEPES buffer
Q7. What is the primary function of phenol red in cell culture media and one known limitation?
- It acts as an energy source and stabilizes amino acids.
- It serves as a pH indicator; however it may interfere with some estrogen receptor assays and fluorescence measurements.
- It prevents bacterial contamination but can cause cell toxicity at low pH.
- It chelates divalent cations and prevents precipitation of salts.
Correct Answer: It serves as a pH indicator; however it may interfere with some estrogen receptor assays and fluorescence measurements.
Q8. Why is L-glutamine often added fresh to media or replaced by stable alternatives?
- Because L-glutamine promotes fungal growth if stored too long.
- Because L-glutamine is unstable in solution and spontaneously degrades to ammonia, which is toxic.
- Because L-glutamine evaporates rapidly at room temperature.
- Because L-glutamine permanently binds to phenol red interfering with pH measurement.
Correct Answer: Because L-glutamine is unstable in solution and spontaneously degrades to ammonia, which is toxic.
Q9. What is the typical osmolality range (mOsm/kg) suitable for most mammalian cell culture media?
- 100–150 mOsm/kg
- 280–320 mOsm/kg
- 400–500 mOsm/kg
- 600–800 mOsm/kg
Correct Answer: 280–320 mOsm/kg
Q10. Which is a major advantage of using serum-free or chemically defined media?
- They always increase cell growth rate compared with serum-containing media.
- They reduce batch-to-batch variability and allow defined experimental conditions and easier regulatory compliance.
- They eliminate the need for sterilization and aseptic technique.
- They require no optimization for different cell lines.
Correct Answer: They reduce batch-to-batch variability and allow defined experimental conditions and easier regulatory compliance.
Q11. Which statement about adding antibiotics (e.g., penicillin-streptomycin) to culture media is correct?
- Antibiotics completely eliminate all contamination risks and require no further aseptic technique.
- Antibiotics prevent bacterial overgrowth but can mask low-level contamination and select for resistant organisms.
- Antibiotics are essential for primary cell cultures and always improve cell physiology.
- Antibiotics replace the need to monitor cultures regularly.
Correct Answer: Antibiotics prevent bacterial overgrowth but can mask low-level contamination and select for resistant organisms.
Q12. What pore size is commonly used for sterile filtration of culture media to remove bacteria?
- 0.01 µm
- 0.22 µm
- 0.45 µm
- 1.2 µm
Correct Answer: 0.22 µm
Q13. What is a primary use of balanced salt solutions such as PBS or HBSS in cell culture?
- As a long-term complete growth medium replacing serum.
- Washing cells, transporting cells and short-term maintenance during manipulations.
- As an antibiotic supplement to prevent contamination.
- As a stain for viability assays.
Correct Answer: Washing cells, transporting cells and short-term maintenance during manipulations.
Q14. What is the role of sodium pyruvate when added to many culture media?
- It is a pH indicator that changes color with metabolic activity.
- It serves as an extra carbon/energy source and can support cells under metabolic stress.
- It chelates divalent cations to prevent precipitation.
- It functions as an antibiotic to suppress bacterial growth.
Correct Answer: It serves as an extra carbon/energy source and can support cells under metabolic stress.
Q15. Which of the following is a commonly used human-derived serum alternative for expansion of human mesenchymal and other primary cells?
- Foetal bovine serum (FBS)
- Human platelet lysate (HPL)
- Bovine serum albumin only
- Yeast extract
Correct Answer: Human platelet lysate (HPL)
Q16. Which antibiotic combination is most commonly supplied as a standard antimicrobial supplement in mammalian cell culture?
- Penicillin–streptomycin
- Gentamicin alone
- Amphotericin B alone
- Tetracycline plus chloramphenicol
Correct Answer: Penicillin–streptomycin
Q17. What does the term “conditioned medium” refer to?
- Fresh medium containing only salts and glucose but no cells.
- Medium collected from cultured cells that contains secreted growth factors, cytokines and metabolites.
- Medium that has been heated to inactivate serum components.
- Lyophilized medium powder before reconstitution.
Correct Answer: Medium collected from cultured cells that contains secreted growth factors, cytokines and metabolites.
Q18. Which term best describes media where specific growth factors, hormones and supplements are added at known concentrations to support particular cell types?
- Complex undefined medium
- Chemically defined and supplemented medium
- Conditioned serum
- Selective agar medium
Correct Answer: Chemically defined and supplemented medium
Q19. Why is mycoplasma contamination particularly problematic in cell culture?
- Mycoplasma cause immediate turbidity and are easy to spot visually.
- Mycoplasma are tiny, often do not change turbidity or morphology dramatically, and require specific PCR or biochemical tests for detection.
- Mycoplasma infections are prevented by routine 0.22 µm filtration of media.
- Mycoplasma contamination can be completely controlled by increasing serum concentration.
Correct Answer: Mycoplasma are tiny, often do not change turbidity or morphology dramatically, and require specific PCR or biochemical tests for detection.
Q20. What is GlutaMAX (L-alanyl-L-glutamine) used for in modern cell culture media?
- As a pH indicator alternative to phenol red.
- As a stable dipeptide alternative to L-glutamine that reduces ammonia accumulation and increases shelf-life.
- To chelate calcium and prevent cell adhesion.
- As an antibiotic to prevent bacterial contamination.
Correct Answer: As a stable dipeptide alternative to L-glutamine that reduces ammonia accumulation and increases shelf-life.